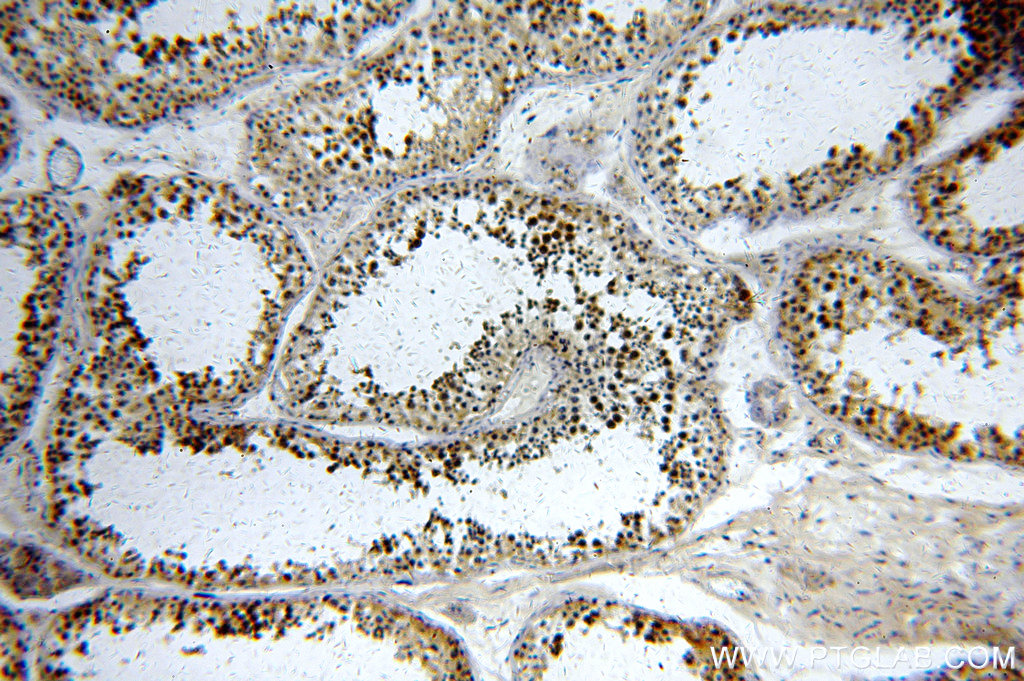

验证数据展示
经过测试的应用
| Positive WB detected in | A431 cells, HeLa cells, Raji cells, A549 cells, HepG2 cells, MCF-7 cells |
| Positive IP detected in | Raji cells |
| Positive IHC detected in | human testis tissue Note: suggested antigen retrieval with TE buffer pH 9.0; (*) Alternatively, antigen retrieval may be performed with citrate buffer pH 6.0 |
| Positive IF/ICC detected in | MCF-7 cells |
推荐稀释比
| 应用 | 推荐稀释比 |
|---|---|
| Western Blot (WB) | WB : 1:1000-1:6000 |
| Immunoprecipitation (IP) | IP : 0.5-4.0 ug for 1.0-3.0 mg of total protein lysate |
| Immunohistochemistry (IHC) | IHC : 1:20-1:200 |
| Immunofluorescence (IF)/ICC | IF/ICC : 1:200-1:800 |
| It is recommended that this reagent should be titrated in each testing system to obtain optimal results. | |
| Sample-dependent, Check data in validation data gallery. | |
产品信息
20590-1-AP targets AIM2 in WB, IHC, IP, ELISA applications and shows reactivity with human samples.
| 经测试应用 | WB, IHC, IP, ELISA Application Description |
| 文献引用应用 | WB, IHC |
| 经测试反应性 | human |
| 文献引用反应性 | human, mouse, rat, zebrafish |
| 免疫原 |
CatNo: Ag14520 Product name: Recombinant human AIM2 protein Source: e coli.-derived, PGEX-4T Tag: GST Domain: 1-343 aa of BC010940 Sequence: MESKYKEILLLTGLDNITDEELDRFKFFLSDEFNIATGKLHTANRIQVATLMIQNAGAVSAVMKTIRIFQKLNYMLLAKRLQEEKEKVDKQYKSVTKPKPLSQAEMSPAASAAIRNDVAKQRAAPKVSPHVKPEQKQMVAQQESIREGFQKRCLPVMVLKAKKPFTFETQEGKQEMFHATVATEKEFFFVKVFNTLLKDKFIPKRIIIIARYYRHSGFLEVNSASRVLDAESDQKVNVPLNIIRKAGETPKINTLQTQPLGTIVNGLFVVQKVTEKKKNILFDLSDNTGKMEVLGVRNEDTMKCKEGDKVRLTFFTLSKNGEKLQLTSGVHSTIKVIKAKKKK 种属同源性预测 |
| 宿主/亚型 | Rabbit / IgG |
| 抗体类别 | Polyclonal |
| 产品类型 | Antibody |
| 全称 | absent in melanoma 2 |
| 别名 | Interferon-inducible protein AIM2, PYHIN4 |
| 计算分子量 | 343 aa, 39 kDa |
| 观测分子量 | 39-42 kDa |
| GenBank蛋白编号 | BC010940 |
| 基因名称 | AIM2 |
| Gene ID (NCBI) | 9447 |
| RRID | AB_10694420 |
| 偶联类型 | Unconjugated |
| 形式 | Liquid |
| 纯化方式 | Antigen affinity purification |
| UNIPROT ID | O14862 |
| 储存缓冲液 | PBS with 0.02% sodium azide and 50% glycerol, pH 7.3. |
| 储存条件 | Store at -20°C. Stable for one year after shipment. Aliquoting is unnecessary for -20oC storage. |
背景介绍
Absent in melanoma 2 (AIM2) is a sensor of cytosolic DNA that is responsible for activation of the inflammasome and host immune responses to DNA viruses and intracellular bacteria (PMID:22695634). Upon binding to DNA, it is thought to undergo oligomerization and to associate with PYCARD initiating the recruitment of caspase-1 precusrsor and processing of interleukin-1 beta and interleukin-18. Otherwise, it functions as a tumor suppressor which may act by repressing NF-kappa-B transcriptional activity (PMID:16432157,20566831). It has been reported that AIM2 protein levels are significantly elevated in alveolar macrophages of patients with IPF and bleomycin-treated mice (PMID: 38078661). AIM2 inflammasome was also significantly activated, which was also confirmed in Aβ-treated microglial cells (PMID: 34861878)
实验方案
| Product Specific Protocols | |
|---|---|
| IF protocol for AIM2 antibody 20590-1-AP | Download protocol |
| IHC protocol for AIM2 antibody 20590-1-AP | Download protocol |
| IP protocol for AIM2 antibody 20590-1-AP | Download protocol |
| WB protocol for AIM2 antibody 20590-1-AP | Download protocol |
| Standard Protocols | |
|---|---|
| Click here to view our Standard Protocols |
发表文章
| Species | Application | Title |
|---|---|---|
Cell Mol Immunol NLRP3-dependent pyroptosis is required for HIV-1 gp120-induced neuropathology.
| ||
Mucosal Immunol AIM2 contributes to the maintenance of intestinal integrity via Akt and protects against Salmonella mucosal infection. | ||
J Agric Food Chem Integrative Gut Microbiota and Metabolomic Analyses Reveal the PANoptosis- and Ferroptosis-Related Mechanisms of Chrysoeriol in Inhibiting Melanoma | ||
Front Immunol Cytokine Secretion and Pyroptosis of Thyroid Follicular Cells Mediated by Enhanced NLRP3, NLRP1, NLRC4, and AIM2 Inflammasomes Are Associated With Autoimmune Thyroiditis. | ||
Front Cell Dev Biol Autophagy-Based Unconventional Secretory for AIM2 Inflammasome Drives DNA Damage Resistance During Intervertebral Disc Degeneration.
| ||
Front Immunol Crosstalk of necroptosis and pyroptosis defines tumor microenvironment characterization and predicts prognosis in clear cell renal carcinoma |